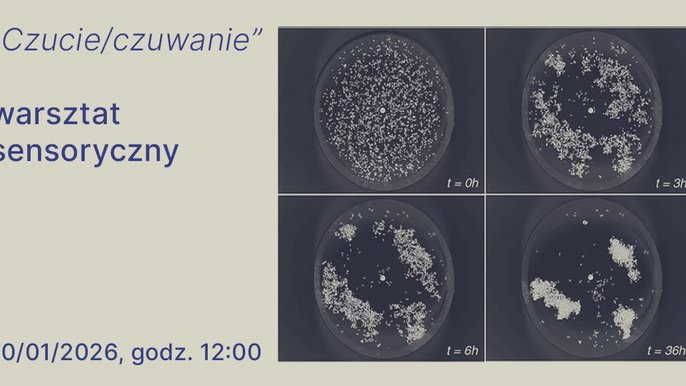

Biegaj w Łodzi
Serwus!
Jestem Konrad, jeden z tysięcy łódzkich biegaczy, ultramaratończyk. Na tej stronie znajdziesz mój wybór popularnych miejsc w Łodzi, gdzie w spokoju pobiegasz i nie nawdychasz się spalin. Zachęcam Cię też do startów w łódzkich biegach. Jedni z Was lubią klepać kilometry po równych, utwardzonych nawierzchniach, inni wolą biegać wokół drzew po trawiastych wzniesieniach, a takich miejsc czy zawodów w naszym mieście nie brakuje.
Łódź oferuje ogrom biegowych możliwości, zatem odkrywaj to miasto i miłej zabawy!
Doświadczeni biegacze od dawna mają swoje ulubione trasy, a i ci, którzy dopiero rozpoczynają swoją biegową przygodę, mogą wskazać przyjazne nam miejsca. Podobnie jest z zawodami, w których startujecie w Łodzi, bo jednym spodoba się taka formuła i trasa, a pozostali zachwycą się czymś zupełnie innym. Ilu biegaczy, tyle gustów. Dlatego chętnie poznam Wasze preferencje, propozycje, bo razem możemy rozbudowywać tę stronę. Czego Wam tu jeszcze brakuje? Piszcie do mnie na adres: k.ciezki@uml.lodz.pl
Biegowe aktualności
Czucie/czuwanie │ warsztat sensoryczny towarzyszący wystawie „Perfumeryzm” w Kamienicy Hilarego Majewskiego
Podczas warsztatu sprawdzimy czy nasze nosy… więcej

Tajemnice roślin: warsztat dla dzieci z tworzenia zielnika w Muzeum Farmacji
Czy rośliny mogą nam pomagać? Gdzie możemy je… więcej

HALO, BAZA? vol. 2 / warsztaty z projektowania z Anną Ucińską w Kamienicy Hilarego Majewskiego
Zapraszamy na kolejne warsztaty z projektowania… więcej

Oprowadzanie kuratorskie po wystawie „Ucząc się od Łodzi 2: Bałuty” w Kamienicy Hilarego Majewskiego
Ostatnie oprowadzanie przed finisażem! więcej

Fotospacer po Bałutach i twórcze warsztaty dla młodzieży i dzieci
Zapraszamy dzieci i młodzież na wyjątkową przygodę… więcej

Warsztaty Rodzinne: Łódź w Baśni i Legendzie w MTN
Zajęcia, podczas których uczestniczy poznają trzy… więcej







